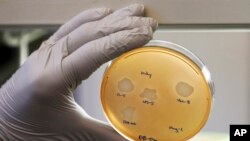

Avrupa Birliği bünyesindeki Avrupa Hastalık Önleme ve Kontrol Merkezi (ECDC), "süper mikrop" olarak bilinen antibiyotiklere dirençli mikropların neden olduğu enfeksiyon vakalarının Avrupa'daki hastanelerde iki kat arttığını bildirdi. Bu açıklama, COVID-19 pandemisinin geniş çaplı etkilerinin yeni bir kanıtı niteliğinde.
ECDC'nin yayınladığı raporda antibiyotiklere dirençli iki mikrobun yol açtığı enfeksiyon vakalarının pandeminin ilk yılı olan 2020'de arttığı, 2021'deyse hızla yükseldiği kaydedildi.
ECDC yetkilisi Dominique Monnet, düzenlediği basın toplantısında, bu hızlı artışın hastanelerin yoğun bakım ünitelerinde ve antibiyotiğe dirençli enfeksiyonların daha önce de yaygın olduğu Avrupa Birliği ülkelerinde görülen süper mikrop salgınlarından kaynaklandığını söyledi.
Veriler, geçen yıl Avrupa'da ‘Acinetobacter’ grubuna giren bakterilerin yol açtığı enfeksiyon vakalarının, pandemi öncesi bildirilen vakalara kıyasla iki kattan fazla arttığına işaret ediyor. Bir başka bakteri türü olan ve son çare olarak başvurulan antibiyotik ilaçlara bile direnç gösteren ‘Klebsiella pneumoniae’ bakterisinin yol açtığı enfeksiyon vakaları ise 2020'de yüzde 31, 2021'deyse yüzde 20 oranında arttı.
Rapor, 2020 ve 2021 yıllarında bu enfeksiyonların kaç kişinin ölümüne yol açtığına ilişkin veri içermiyor. Uzmanlar, COVID-19 nedeniyle hastaneye yatırılan hastaların ölüm nedeninin tam olarak neye bağlı olduğunu belirlemenin zor olduğunu söylüyor.
Bazı uzmanlar, pandemi döneminde hastanelerde bulaşan süper mikrop enfeksiyonlarının artmasını COVID-19'u tedavi etmek için daha fazla antibiyotik kullanılmasına ve uzun hastaneye yatış süreçlerindeki diğer bakteriyel enfeksiyonlara bağlıyor.
Dominique Monnet, bunun "en akla yatkın hipotez" olduğunu, ancak ECDC'nin henüz bu konuda kapsamlı bir analiz yapmadığını söyledi.
Monnet, verilerin, Avrupa'daki hastanelerde sık rastlanan diğer süper mikrop enfeksiyonu vakalarında düşüş olduğunu gösterdiğini kaydetti. ECDC'ye göre bunun nedeni, COVID-19 pandemisinin yarattığı krize bağlı olarak hastanelerin bazı ameliyatları ertelemek zorunda kalması.
ECDC raporu, Amerika'da gözlenen bir eğilimle de benzerlik gösteriyor. Amerikan hükümeti verileri, 2020 yılında antibiyotik direnci gösteren enfeksiyon vakalarının yol açtığı ölümlerde yüzde 15'lik artış olduğunu ortaya koyuyor.
Antibiyotik direnci, antibiyotiklerin yanlış ya da gereğinden fazla kullanılmasıyla ortaya çıkan bir durum.
Antibiyotik direncine ilişkin kaygılarsa yeni değil. Uzmanlar, mantar enfeksiyonları dahil süper mikropların yol açtığı enfeksiyonları, yılda bir milyondan fazla kişinin ölümüne yol açan, ancak dikkat çekmeyen sessiz bir pandemi olarak tanımlıyor. Bu tür enfeksiyonlarla ilgili araştırmalara ayrılan fonlar da yetersiz.